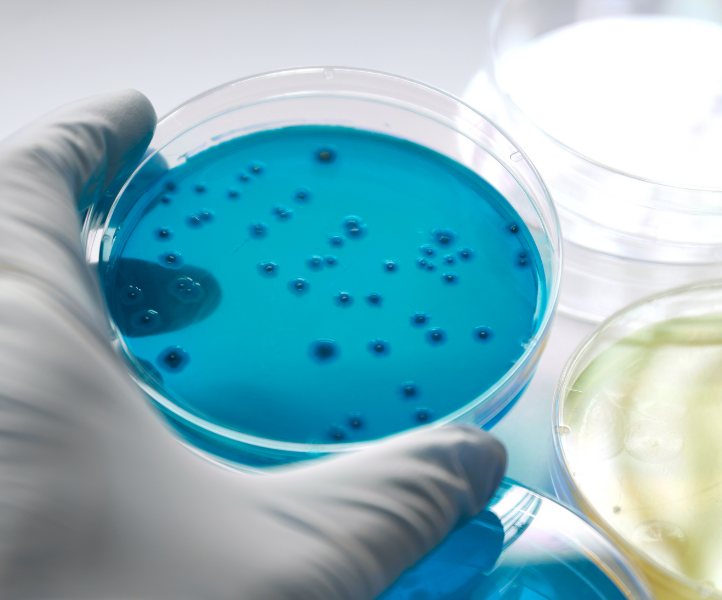

Challenge Test (Teste de eficácia ao sistema conservante)
O teste de eficácia ao sistema conservante é fundamental para avaliar a capacidade conservante de uma formulação cosmética. Os conservantes antimicrobianos são adicionados aos produtos cosméticos com o objetivo de matar ou inibir o crescimento de microbiano uma vez que, durante a utilização do produto, poderão ser introduzidos inadvertidamente diversos microrganismos patogénicos.
A ISO 11930 é atualmente o método internacionalmente reconhecido para a realização deste teste.
A Pharmilab está acreditada como Laboratório de Ensaios, segundo a norma NP EN ISO/IEC 17025:2018″










